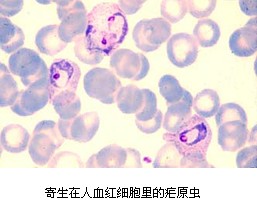

4.26“全国疟疾日”宣传主题-携手联防联控,降低疟疾危害
时间:2009-04-25
浏览量:3430
4.26全国疟疾日
2009年宣传主题------携手联防联控,降低疟疾危害
一、4.26全国疟疾日的由来
疟疾是全球广泛关注的重要公共卫生问题之一,降低疟疾发病率,减轻疟疾疾病负担已列入《联合国千年发展目标》。2007年5月,第六十届世界卫生大会通过决议,决定从2008年起将每年4月25日或个别成员国决定的一日作为世界疟疾日,要求各成员国、有关国际组织和民间团体,以适当形式开展世界疟疾日防治宣传活动。根据上述决议,结合我国实际情况,卫生部决定将每年的
二、疟疾是一种什么样的疾病?患疟疾的病人主要有哪些临床表现?
疟疾是一种由疟原虫引起,经蚊子(按蚊)叮咬而传播的重要寄生虫病,与结核、艾滋病一起并列为全球最严重的三大传染病。


患了疟疾的病人主要的临床表现为:周期性发冷、发热、出汗等症状,如发病时间较长,可出现脾肿大、贫血等。由于所感染疟原虫的种、株差异以及病人的免疫状态的强弱,临床表现也轻重不一。如果感染恶性疟,又未及时诊治,可出现高热、剧烈头痛呕吐、昏迷,严重者可发生脑水肿,呼吸衰竭而死亡。 三、当前疟疾流行情况 世界每年感染疟疾3.5-5亿人、死亡110万人(每天死亡3000人)。疟疾流行主要分布在非洲(59%)、亚洲(38%)、美洲(3%)。 云南省疟疾发病主要在47个县,其中与缅甸、老挝、越南相邻的25个边境县为疟疾高发区。2001-2008年,我省共报告发病88238例,其中1/4来自境外感染。 四、如何预防疟疾? 一是及时发现并根治疟疾现症病人,防止病人被可以传播疟疾的按蚊叮咬后再将疟原虫传播给健康人;二是灭蚊,结合农田水利建设和爱国卫生运动,消灭按蚊幼虫及其孳生场所,填平积水坑洼,清除杂草,稻田养鱼吞食幼虫等;合理使用杀虫剂灭蚊,滞留喷洒或浸泡蚊帐;三是自我防护,改变户外露宿习惯,合理使用蚊帐,居室安装纱窗纱门,使用蚊香,驱蚊器和涂抹防护油膏等;如前往高疟区,可定期服用预防药物进行预防。 五、云南省寄生虫病防治所 该所是我省疟疾等寄生虫病防治指导的省级权威机构。除开展常规防治工作外,还进行科学研究、研究生培养及专业人员培训等工作。目前,我所在省卫生厅的领导下,正在全省实施全球基金疟疾项目和中缅、中越部分地区疟疾联防联控试点项目,通过加强与毗邻国家的交流,携手联防联控,降低疟疾危害。 疟疾可防可治不可怕, 如果您感染了疟疾, 请及时到各地卫生院、医院或疾病预防控制中心就诊! 云南省寄生虫病防治所 宣